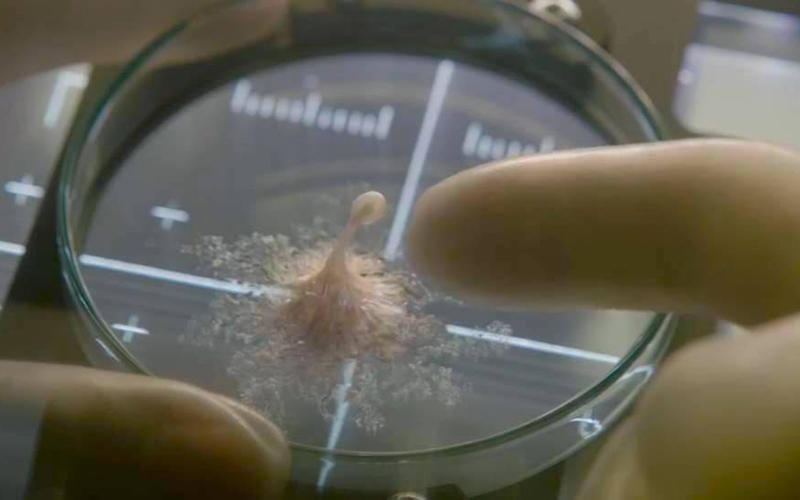

Ένας διεθνής διαστημικός σταθμός βρίσκεται στα πρόθυρα μίας εκ των μεγαλύτερων ανακαλύψεων στην ανθρώπινη ιστορία: την πρώτη απόδειξη ζωής στον πλανήτη Άρη. Καθώς το εξαμελές πλήρωμα προχωράει στην εξερεύνηση, οι μέθοδοι τους καταλήγουν να έχουν ακούσιες συνέπειες, και η μορφή ζωής που εντόπισαν αποδεικνύεται πιο ευφυής από ό,τι περίμεναν όλοι.
Ένας διεθνής διαστημικός σταθμός βρίσκεται στα πρόθυρα μίας εκ των μεγαλύτερων ανακαλύψεων στην ανθρώπινη ιστορία: την πρώτη απόδειξη ζωής στον πλανήτη Άρη. Καθώς το εξαμελές πλήρωμα προχωράει στην εξερεύνηση, οι μέθοδοι τους καταλήγουν να έχουν ακούσιες συνέπειες, και η μορφή ζωής που εντόπισαν αποδεικνύεται πιο ευφυής από ό,τι περίμεναν όλοι.
Σκηνοθεσία:
Κύριοι Ρόλοι:
Jake Gyllenhaal … Δρ David Jordan
Rebecca Ferguson … Δρ Miranda North
Ryan Reynolds … Rory Adams
Hiroyuki Sanada … Sho Murakami
Ariyon Bakare … Δρ Hugh Derry
Olga Dykhovichnaya … Ekaterina Golovkina
Κεντρικό Επιτελείο:
Σενάριο: Rhett Reese, Paul Wernick
Παραγωγή: Bonnie Curtis, David Ellison, Dana Goldberg, Julie Lynn
Μουσική: Jon Ekstrand
Φωτογραφία: Seamus McGarvey
Μοντάζ: Mary Jo Markey, Frances Parker
Σκηνικά: Nigel Phelps
Κοστούμια: Jenny Beavan
Διεθνής Κριτική (μ.ο.): Μέτρια.
Τίτλοι
- Αυθεντικός Τίτλος: Life
- Ελληνικός Τίτλος: Life
Παραλειπόμενα
- Τον βασικό χαρακτήρα προορίζονταν να τον ερμηνεύσει ο Ryan Reynolds. Το πρόγραμμα του όμως δεν έβγαινε, και περιορίστηκε στον βοηθητικό ρόλο.
- Αρχικά, η Rebecca Ferguson δεν ήθελε να παίξει στην ταινία, επικαλούμενη φοβίες για μια ταινία τέτοιου βεληνεκούς. Εντέλει την έπεισε ο σκηνοθέτης.
- Κάποιες φήμες ήθελαν το φιλμ να είναι πρίκουελ του Venom. Αυτό ξεκίνησε μετά τη χρήση αντιδράσεων κοινού για το Spider-Man 3 στο πρώτο trailer της ταινίας.
- Η Paramount Pictures ήταν η πρώτη που διεκδίκησε τα δικαιώματα διανομής, πριν αυτά καταλήξουν στη Sony Pictures.
- Όλα τα εφέ έγιναν από την Double Negative, με εξαίρεση τον αρχικό 8λεπτο μονόπλανο που ανέλαβε η Industrial Light & Magic.
Κριτικός: Πάνος Αχτσιόγλου
Έκδοση Κειμένου: 26/3/2017
Ταινίες με θέμα την εξωγήινη απειλή αποτελούν διαχρονικά αντικείμενο ανάλυσης και στοχασμού, όχι τόσο για τη ρητή τους αναπαράσταση, όσο για αυτό που πολλές φορές κρύβεται κάτω από την επιφάνεια της γεμάτης αγωνία πλοκής τους. Ο κίνδυνος του αγνώστου, αντηχώντας κάθε κοινωνικό, πολιτικό ή ακόμη και ψυχαναλυτικό συνειρμό, εξυπηρετεί με τον τρόπο του την αφήγηση, δίνοντας διαφορετική διάσταση στους αρχέγονους φόβους που μπορούν εύστοχα να συνοψίζονται στην ερώτηση «είμαστε μόνοι στο σύμπαν;». Αν και αυτό φαίνεται να το γνωρίζει πολύ καλά η νέα ταινία του σκηνοθέτη Ντάνιελ Εσπινόζα («Το Κρησφύγετο» «Child 44»), ωστόσο αναλαμβάνει να βασιστεί σε παραδοσιακούς μηχανισμούς πυροδότησης της έντασης που την καθιστούν ελκυστική αποκλειστικά και μόνο στους ορκισμένους φαν του συγκεκριμένου είδους, οι οποίοι με τη σειρά τους απολαμβάνουν να αναγνωρίζουν τις άρρηκτα συνδεδεμένες κινηματογραφικές συμβάσεις και τις εξόφθαλμες παραπομπές σε γνωστά αριστουργήματα. Όπως είναι προφανές, όταν ένα φιλμ αποφασίζει τελικά να βαδίσει αυτό τον δρόμο, οι συγκρίσεις είναι δυστυχώς αναπόφευκτες και το αποτέλεσμα φαντάζει μάλλον προκαθορισμένο.
Το πολυεθνικό επιστημονικό πλήρωμα του Διεθνούς Διαστημικού Σταθμού (το οποίο, παρά τη φιλότιμη σεναριακή προσπάθεια, στελεχώνεται πάλι κυρίως από λευκούς Αγγλοσάξονες) θα βρεθεί αντιμέτωπο με μια νέα μορφή ζωής, όταν θα συλλέξει ένα αυτοματοποιημένο σκάφος που φτάνει από τον πλανήτη Άρη περιέχοντας δείγματα προς ανάλυση. Η κάμερα του πολυβραβευμένου ιρλανδού Σίμους ΜακΓκάρβεϊ ελίσσεται, απελευθερωμένη θαρρείς από κάθε περιορισμό, μέσα σε στενούς διαδρόμους και κλειστοφοβικά δωμάτια, ανταγωνιζόμενη τα αργόσυρτα μονοπλάνα του οσκαρικού «Gravity», από το οποίο ξεκάθαρα το φιλμ αντλεί έμπνευση, ιδίως στην πρώτη του πράξη. Όταν όμως ο μονοκύτταρος εξωγήινος οργανισμός που ακούει στο όνομα «Κάλβιν» (sic!) αρχίσει να πολλαπλασιάζεται ανεξέλεγκτα, επιδεικνύοντας ταυτόχρονα εντυπωσιακή δύναμη κι ασύλληπτη προσαρμοστικότητα, τότε η τρομακτική σκιά του αριστουργηματικού «Άλιεν» του 1979 θα πέσει αναπόδραστα πάνω στην ταινία του γεννημένου στη Σουηδία Εσπινόζα, ξεσκεπάζοντας (αντί να καλύπτει) μια τετριμμένη αφηγηματική δομή γεμάτη ασαφή κίνητρα, σεναριακές προχειρότητες και κυρίως στερεοτυπική εξέλιξη και κορύφωση. Ακόμη και οι εντυπωσιασμοί των ειδικών εφέ έχουν μια εντελώς γνωστή γεύση, καθώς το εξωγήινο πλάσμα με τις διαφανείς απολήξεις τρυπώνει σε όποιον ανοιχτό αεραγωγό βρει και το τρομοκρατημένο πλήρωμα, στην προσπάθειά του να το περιορίσει, μοιάζει να παίρνει τη μία λανθασμένη απόφαση μετά την άλλη.
Σταδιακά, ακόμη και η ομολογουμένως κομψή σκηνοθεσία θα υποκύψει κάτω από το βάρος των κλισέ, αφού οι σκηνές που μας πληροφορούν για τις προσωπικές ιστορίες καθενός από τα μέλη του πληρώματος (το οποίο παρεμπιπτόντως απαρτίζεται από ένα διόλου αδιάφορο καστ, που περιλαμβάνει μεταξύ άλλων τους Τζέικ Τζίλενχαλ, Ράιαν Ρέινολντς και Χιρογιούκι Σανάντα) αποδεικνύονται σε μεγάλο βαθμό ανούσιες, δίνοντας την αίσθηση ότι χρησιμεύουν μόνο ως μεθοδευμένες τακτικές μείωσης του ρυθμού, πριν από τον επόμενο αποτρόπαιο θάνατο που θα προωθήσει αναπόφευκτα την πλοκή προς την προδιαγεγραμμένη της εξέλιξη. Μόνος ενδιαφέρων, «τρισδιάστατος» και ερμηνευτικά πειθαρχημένος χαρακτήρας δείχνει η Ρεμπέκα Φέργκιουσον, αποτυπώνοντας στη συμπεριφορά της την απόλυτα ανθρώπινη συνθήκη που θέλει ακόμη και τους εξυπνότερους και κατάλληλα προετοιμασμένους επαγγελματίες να παίρνουν τελικά τις πιο ανήθικες αποφάσεις προκειμένου να σώσουν τη ζωή τους.
Ο σκηνοθέτης αποφασίζει ουσιαστικά να επαναφέρει στη ζωή την ταινία του προς το φινάλε (υιοθετώντας μια αποδοτική αλλά εξίσου προβλέψιμη ανατροπή), όμως μοιάζει ήδη πολύ αργά. Αυτό που μένει τελικά ως συμπέρασμα είναι ότι το «Life» συνιστά ένα μάλλον ημιθανές μείγμα από συμβάσεις διαστημικών θρίλερ επιβίωσης, που μπορεί σε στιγμές να αποδίδουν ψήγματα σασπένς, αλλά στο σύνολό τους συνθέτουν ένα αχρείαστο αποτέλεσμα που στερείται δημιουργικότητας και κυρίως αυθεντικότητας. Δίνοντας ακούσια την εντύπωση του θεματικού προπομπού του πολυαναμενόμενου «Alien: Covenant», το φιλμ του Εσπινόζα ίσως να μην αποδεικνύεται τελικά κατάφωρα ανιαρό, αλλά σίγουρα φαντάζει προορισμένο για να περάσει γρήγορα στην κινηματογραφική λήθη.
Βαθμολογία:
![]()
![]()
Κριτικός: Σταύρος Γανωτής
Έκδοση Κειμένου: 21/1/2018
Με ένα φινάλε που ανοίγει πεδία, αντί για χάπι-εντ, ο Ντανιέλ Εσπινόζα πασχίζει να σώσει τα προσχήματα σε μία ακόμα αδιάφορη κόπια του κλασικού «Alien». Το βασικότερο πρόβλημα στο φιλμ είναι οι χαρακτήρες. Αν ήταν ένα ντοκιουντράμα που αφορούσε κάποιο αληθινό περιστατικό, θα τους δεχόμαστε ως είναι, επικεντρωμένοι στο γεγονός. Μα, έχοντας μυθοπλασία και μάλιστα μέτριου σεναρίου και δράσης, δύσκολα ο θεατής αγωνιά για τη μοίρα τους. Το δεύτερο θέμα που ενσκήπτει εδώ, είναι πως έχουμε μια ταινία διαστήματος, κάτι που έχει καθιερωθεί να συνδέεται με την ανθρώπινη ευφυΐα. Αλλά πέρα του ότι πράγματι οι ήρωες είναι έξυπνοι, δεν υπάρχει κανενός είδους φιλοσοφία επί του θέματος, ή κάτι που να παραπέμπει σε υψηλή διανόηση. Αδιάφορες περνάν και οι ερμηνείες, ειδικά του Τζέιν Τζίλενχααλ και του Ράιαν Ρέινολντς, με τη Ρεμπέκα Φέργκιουσον να κερδίζει στα σημεία τη συγκεκριμένη «μάχη».
Βαθμολογία:
![]()
![]()


 Κριτικός:
Κριτικός:  Κριτικός:
Κριτικός: